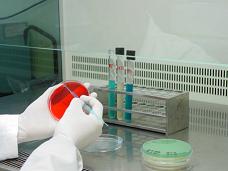
Siembra en placa de petri para aislamiento de bacterias

[12/11/13]
Tras las restricciones impuestas por Rusia en marzo de 2013 a la exportación de productos de origen animal de España a la Unión Aduanera de Eurasia (UA), formada por Rusia, Bielorrusia y Kazajstán, se establecieron procedimientos de autocontrol y de control oficial exigibles a las empresas que quieran exportar carne y productos cárnicos a países miembros de la Unión Aduanera con el fin de garantizar el cumplimiento de los requisitos sanitarios establecidos por la UA.
El Ministerio de Sanidad, en colaboración con las CCAA, elaboró un listado de laboratorios autorizados para el control oficial de las muestras de carne y productos cárnicos destinados a la UA, entre los que se encuentra el Laboratorio Regional, recibiendo la autorización concretamente para el análisis de residuos de medicamentos y análisis microbiológicos.
Paralelamente, el Laboratorio Regional fue autorizado por parte del Ministerio de Sanidad para la realización de análisis de Salmonella y Listeria en el marco de la exportación de carne y productos cárnicos a EEUU. Para ello, el Laboratorio solicitó la equivalencia de sus métodos con los que se llevan a cabo en EEUU; una vez aceptados por parte del Food Safety and Inspection Service (FSIS) del Departamento de Agricultura de EEUU, y tras pasar auditoría del Ministerio de Sanidad, se recibió la autorización para realizar estos análisis.